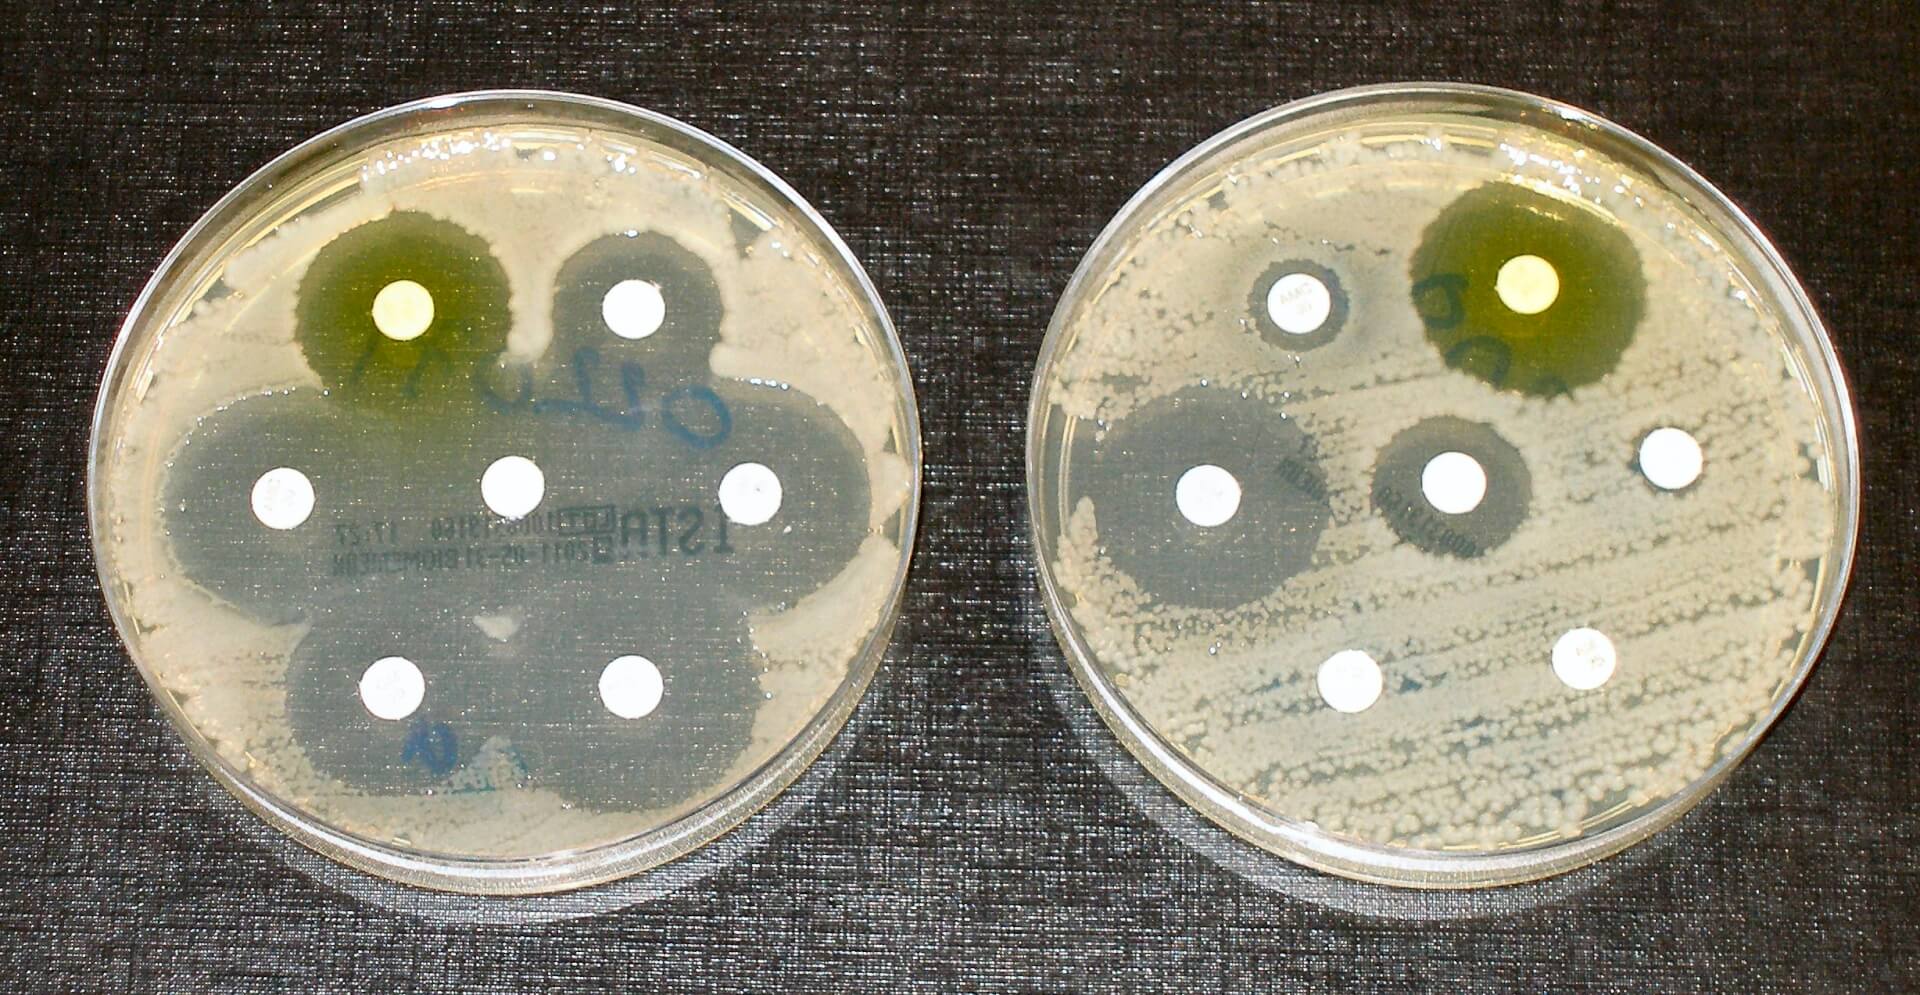

Onverhit varkensvlees en met name rauwe varkenslever, is waarschijnlijk de belangrijkste besmettingsbron van Hepatitis E. Diverse recente Europese studies wijzen steeds duidelijker in die richting, zegt professor en onderzoeker Wim van der Poel van Wageningen Bioveterinary Research.
Uit het in juli 2017 gepubliceerde rapport van de European Food Safety Association (EFSA) blijkt dat het aantal klinische gevallen van Hepatitis E-virus (HEV) stijgt. In de afgelopen 10 jaar waren er 21.000 patiënten met duidelijke ziekteverschijnselen in Europa. Dat is tien keer zoveel als in de tien jaar daarvoor. De meeste gevallen zijn gerapporteerd uit Frankrijk, Duitsland en het Verenigd Koninkrijk. Met daarbij de kanttekening dat het niet in alle lidstaten goed wordt bijgehouden. Mogelijk komt het dus vaker voor.
De recente studies laten zien dat onvoldoende verhit varkensvlees, of vlees van wilde zwijnen of herten de belangrijkste bron van de besmetting met HEV is. De kans dat een mens via andere bronnen besmet raakt is waarschijnlijk kleiner. Lastig is dat de studies HEV aantonen met behulp van DNA-onderzoek. Dat wil dan niet zeggen dat het virus altijd nog een infectie kan veroorzaken. Er lopen nu meerdere onderzoeken die wel moeten kunnen aantonen of het virus nog infectieus is.
Het advies is in ieder geval om geen rauw varkensvlees, of wild te eten en dan vooral geen lever. De kans op rauw vlees is volgens Van der Poel het grootste bij ambachtelijke vleesproducten, zoals gedroogde worsten. Daarbij wordt nog regelmatig rauwe lever verwerkt. “In Frankrijk moet er op die producten een sticker zitten waar dit op staat vermeld.”
De besmetting van de Nederlandse varkensstapel is hoog, maar stabiel rond de vijftig procent. Van der Poel: “Als een stapel eenmaal is besmet raak je de besmetting vrijwel niet meer kwijt. Of een hoge mate van bio-security echt kan voorkomen dat een varkensstapel besmet raakt, is niet duidelijk.”
Lees ook
Meest gelezen
Blogs




Bedrijf in Beeld

Partners